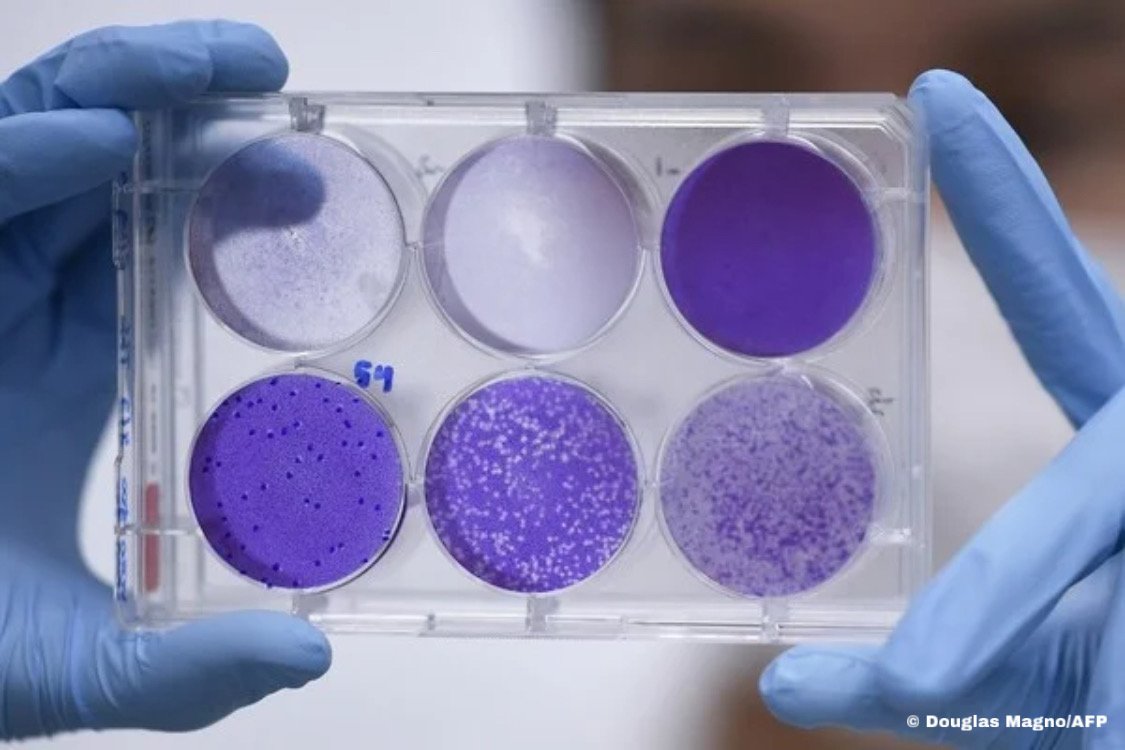

O Brasil chegou a 600.077 mortos pela Covid, divulgou o consórcio de veículos de imprensa em boletim extra na tarde desta sexta-feira (8). Em casos confirmados, são 21.533.752.
A marca foi atingida num momento em que a pandemia está em desaceleração no país. A média de mortes diárias está em 438, o menor número desde novembro do ano passado, e em queda.
Essa desaceleração se expressa também no tempo que a doença levou para tomar mais 100 mil vidas ao Brasil desde que atingimos a trágica marca de 500 mil mortes: foram 111 dias, o dobro dos 51 dias que o país levou para passar de 400 mil para 500 mil óbitos.
Naquele o momento, morriam em média 2 mil brasileiros por dia – mais de quatro vezes a média atual. Em abril deste ano, pior momento da pandemia, a média passou de 3 mil mortos por dia.
- 1ª morte: 12/3/2020
- 100 mil mortes: 8/8/2020 (149 dias depois)
- 200 mil mortes: 7/1/2021 (152 dias)
- 300 mil mortes: 24/3/2021 (76 dias)
- 400 mil mortes: 29/4/2021 (36 dias)
- 500 mil mortes: 19/6/2021 (51 dias)
- 600 mil mortes: 8/10/2021 (111 dias)
Mas, apesar de o número de vítimas do vírus ter despencado nos últimos meses, o Brasil ainda é o 3º país com a maior média diária de novas mortes, atrás apenas de Estados Unidos e Rússia.
O país também mantém a marca de ser o que mais registrou vítimas da pandemia em 2021 no mundo: já foram registradas 405 mil mortes por Covid-19 neste ano, mais do que Estados Unidos e Índia e quase o mesmo que todos os 27 países da União Europeia somados.
Fonte: G1


















